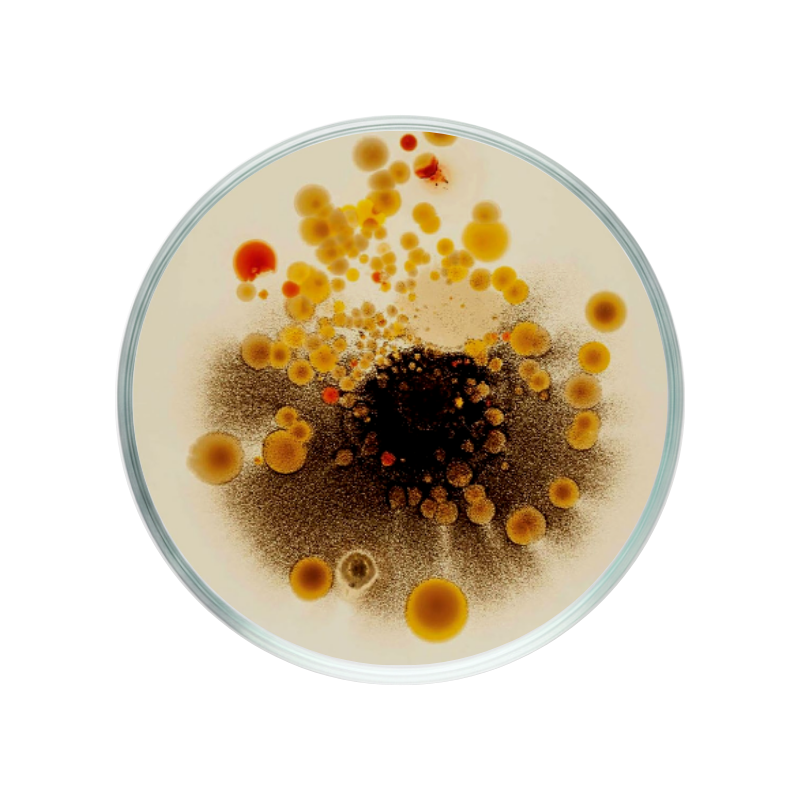

Klinisch onderbouwde ingrediënten






WAAROM INSENTIALS?

Onze filosofie
Onze overtuiging: een symptoom is nooit het echte probleem, de oorzaak wel. De 5E-methode plaatst supplementen binnen een systemische aanpak, waarbij de lever de basis blijft. Gezondheid bouw je op, je belooft het niet.

Wetenschappelijk onderbouwd
Wij zijn een multidisciplinair team dat uitsluitend bestaat uit erkende gezondheidsprofessionals. We beheersen de volledige waardeketen, van R&D tot logistiek, waardoor we de hoogste kwaliteitsnormen kunnen garanderen om jou de ondersteuning te bieden die je nodig hebt.

Gemeten, onderbouwd, geverifieerd
Elke formule is gebaseerd op humane studies, gemeten panels en geverifieerde reviews via Trustpilot. Onderbouwde cijfers, transparante methodologie. Bewijs is voor ons een vereiste voordat een product deel uitmaakt van jouw routine.
Meer effect begint bij een zuivere lever
Combineer Immuniq-10 Boost (Energy Boost) met de 1-2-3 routine.
Immuniq-10 Boost (Energy Boost) werkt het best wanneer je lichaam optimaal kan opnemen.

Combineer Immuniq-10 Boost (Energy Boost) met stap 1 en 2 voor een optimale opname en maximale werking.



Vragen?
Wij helpen je graag.
Bij Insentials weerspiegelt onze prijs de werkelijke kost van kwaliteit zonder compromissen.
1. Wetenschappelijk onderbouwd, niet trendgedreven
Onze formules worden ontwikkeld op basis van wetenschappelijk onderzoek, met zorgvuldig geselecteerde actieve ingrediënten in effectieve doseringen — niet ondergedoseerd voor marketingclaims.
2. Hoogwaardige, traceerbare ingrediënten
Wij werken met premiumgrondstoffen van betrouwbare leveranciers, met focus op zuiverheid, biologische beschikbaarheid en volledige traceerbaarheid. Kwalitatieve ingrediënten kosten nu eenmaal meer en presteren beter.
3. Geen onnodige vulstoffen
Wij focussen op wat werkt. Geen goedkope toevoegingen, geen kunstmatige shortcuts, enkel ingrediënten met een duidelijke, functionele rol.
4. Strenge Europese productienormen
Onze producten worden geproduceerd volgens strikte kwaliteitscontroles. Dat garandeert veiligheid, stabiliteit en consistentie per batch.
5. Langetermijneffect boven kortetermijnmarketing
Wij investeren meer in formulering en kwaliteit dan in agressieve kortingen. Ons doel is duurzame ondersteuning, geen tijdelijke hype.
Kortom: je betaalt niet voor trends. Je investeert in transparantie, wetenschap en bewezen kwaliteit.
Bij Insentials werken we volgens een liver-first filosofie. Wetenschappelijk onderzoek toont aan dat een gezonde lever de basis vormt voor een betere opname en langdurige effectiviteit. Onze formules zijn clean label, science-backed en ontworpen om dag na dag te ondersteunen.
Ja. Veel producten zijn ontworpen om elkaar aan te vullen. Onze packs en routines helpen je hierbij, of je kan persoonlijk advies vragen.
Supplementen werken ondersteunend en hun effect is persoonlijk. We raden aan om producten minstens 3 maanden consequent te gebruiken om hun rol in je routine goed te evalueren.
Ja. We werken met traceerbare ingrediënten, onderbouwde doseringen en selecteren extracten op basis van wetenschappelijke literatuur en kwaliteit.
Gezondheid begint bij de oorzaak
Vanuit die visie ontwikkelde voedingswetenschapper Amandine De Paepe Insentials, met een preventieve focus op levergezondheid.
ACADEMIE
We stand by our science
WE DON'T SELL MIRACLES
Supplementen vragen tijd. Ons team begeleidt je met duidelijke verwachtingen en advies. Contacteer ons na je aankoop.
GRATIS VERZENDING VANAF €45 (BE)
Werelwijde verzending. Bestellingen binnen de EU worden binnen 1–2 werkdagen verzonden.
FLEXIBEL ABONNEMENT
Je kan je levering eenvoudig aanpassen of pauzeren. Annuleren is mogelijk vanaf maand 2.
SPREEK MET ONZE EXPERTS
Ons SciCare-team staat klaar om al je vragen over wetenschap, gezondheid en producten te beantwoorden.
Schrijf je in op de nieuwsbrief en krijg 10% korting op je eerste bestelling.